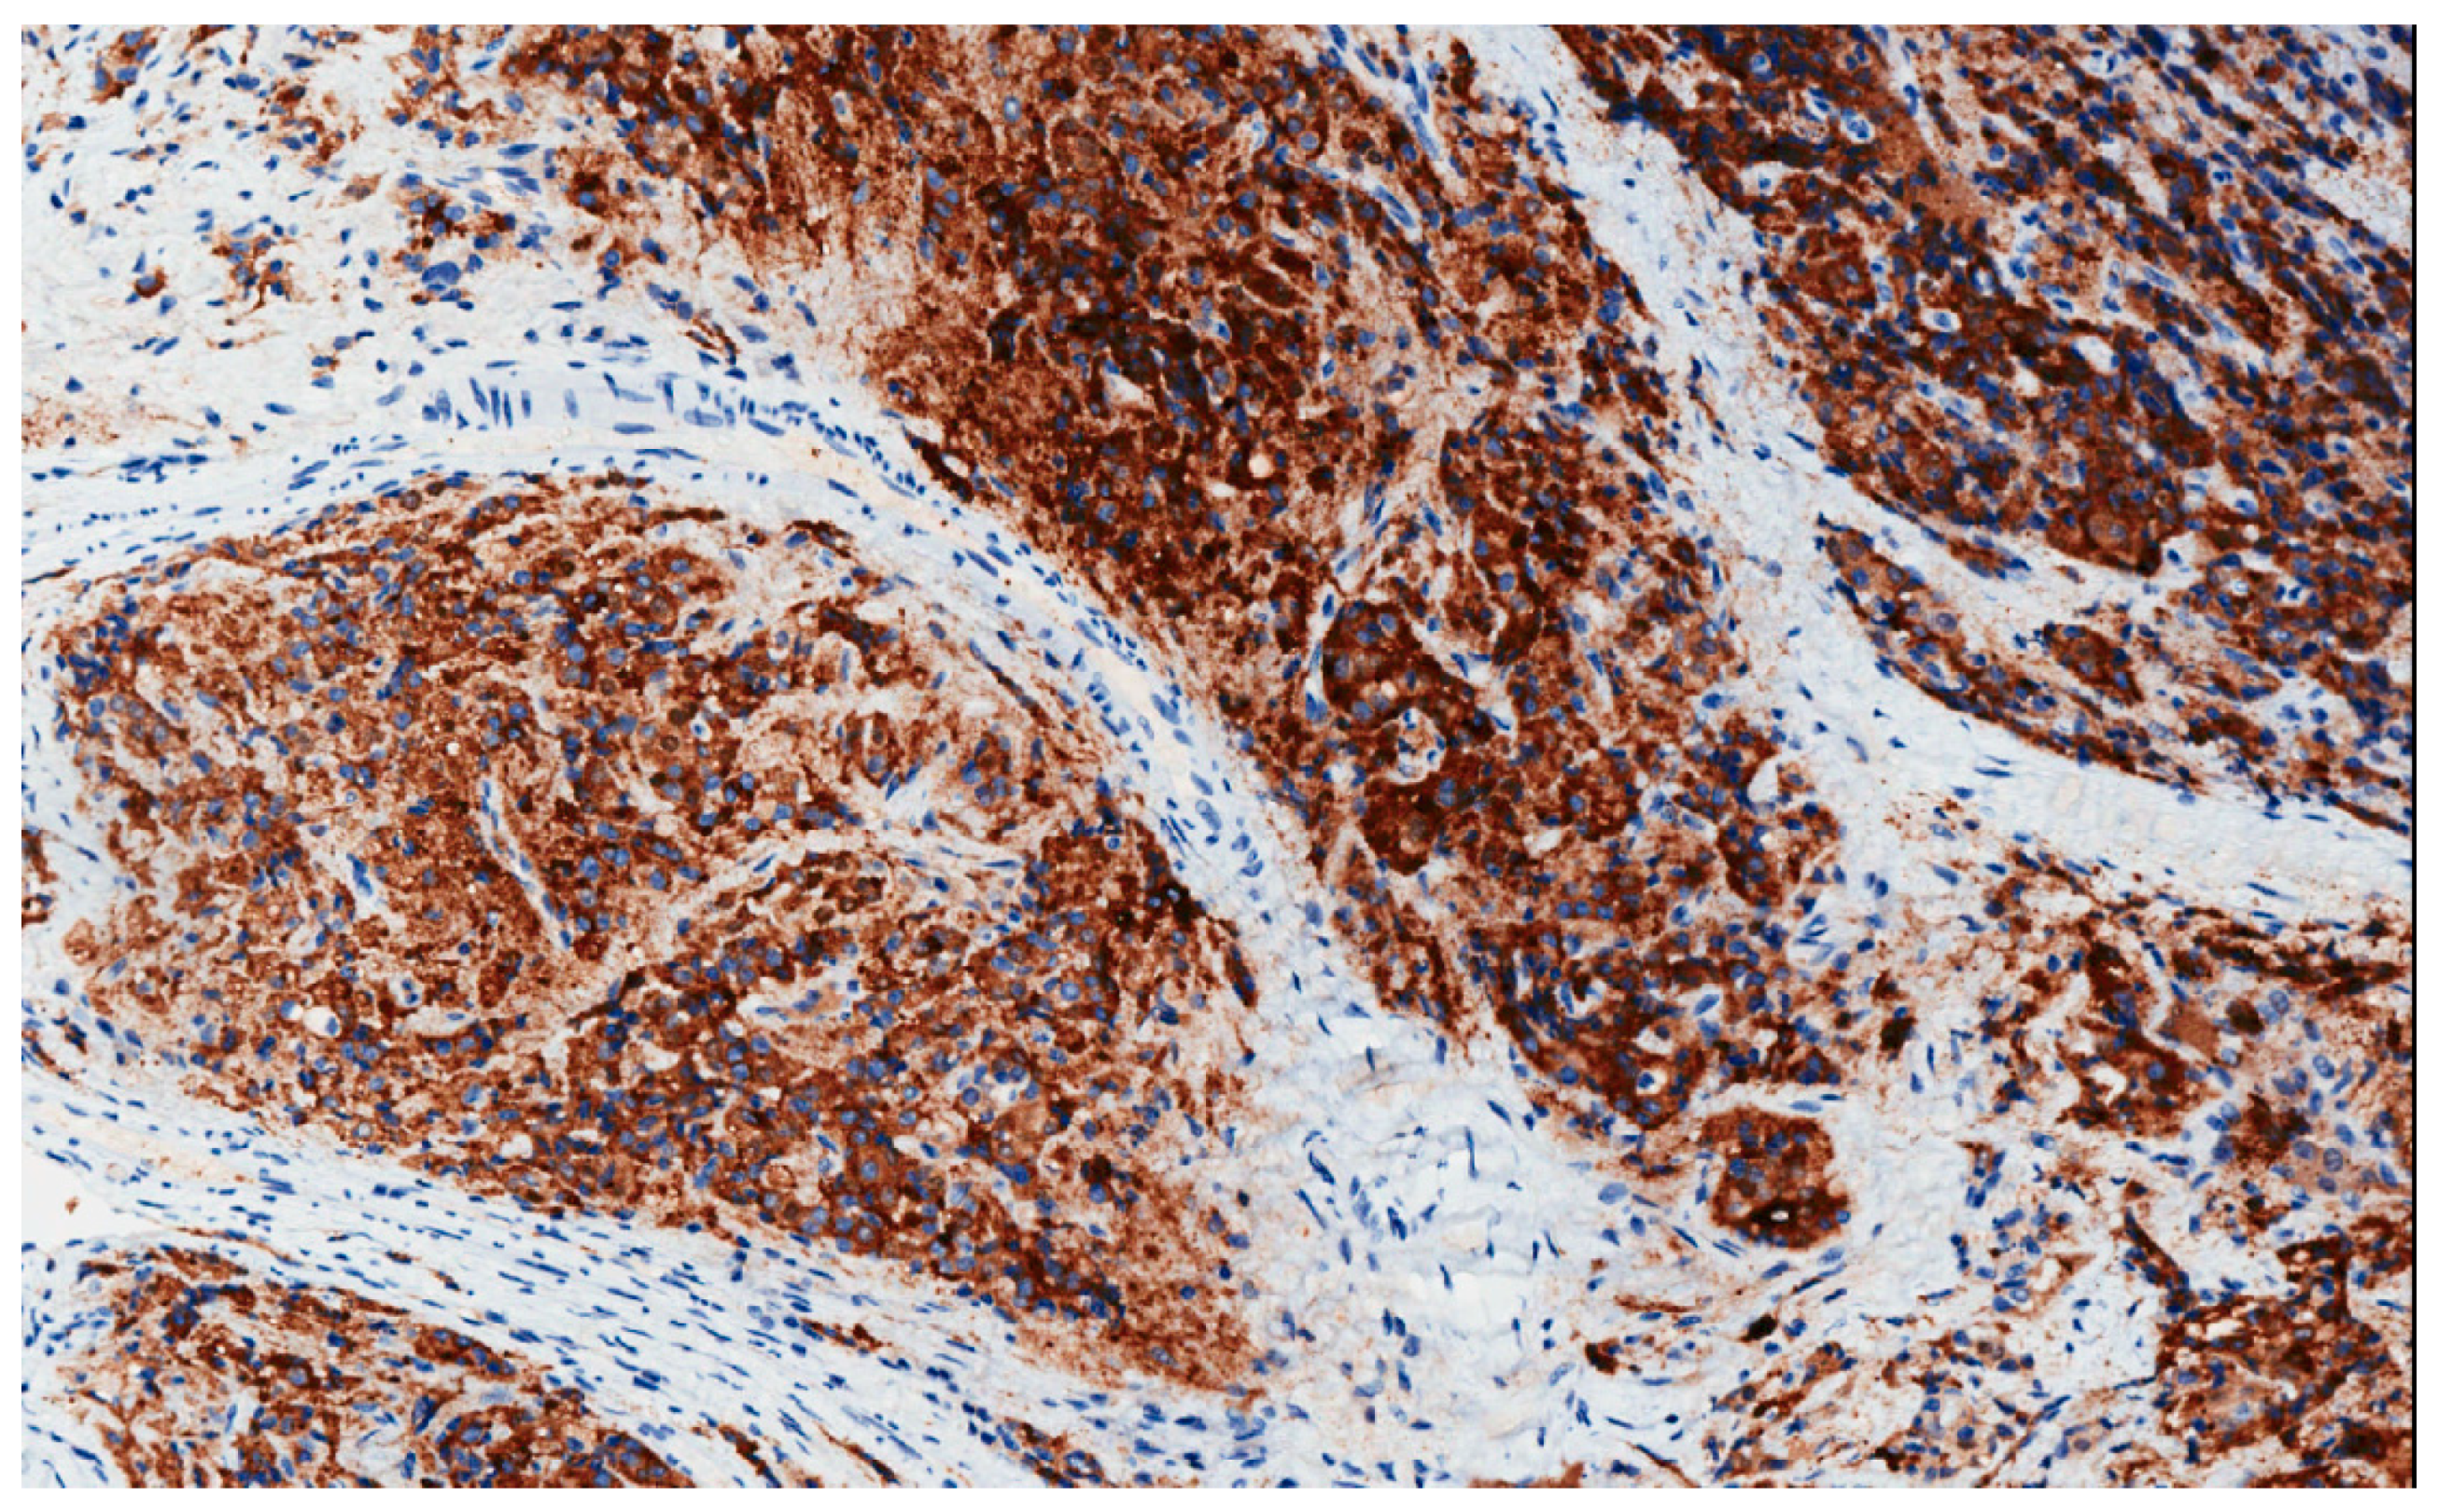

Prostate Cancer in 2021: Novelties in Prognostic and Therapeutic Biomarker Evaluation
Abstract
:Simple Summary
Abstract
1. Introduction
2. PCa Grading
2.1. ISUP and GUPS
2.2. Gleason Grading, Computational Pathology and Artificial Intelligence
3. Aggressive Variant of PCa
4. Molecular Markers Predicting Significant Disease or Response to Therapy
4.1. Mutations to the DNA Damage Repair Pathway and PARPi
4.2. Mutations Other than Defective DNA Repair Mechanisms
4.3. Molecular Markers and Immunotherapy
4.4. Molecular Markers and Liquid Biopsy
4.5. Antibody-Drug Conjugates
4. Conclusions
Author Contributions
Funding
Data Availability Statement
Conflicts of Interest
References
- Montironi, R.; Cimadamore, A.; Lopez-Beltran, A.; Cheng, L.; Scarpelli, M. Update on prostate cancer diagnosis, prognosis, and prediction to response to therapy. Cells 2020, 10, 20. [Google Scholar] [CrossRef]
- Montironi, R.; Santoni, M.; Mazzucchelli, R.; Burattini, L.; Berardi, R.; Galosi, A.B.; Cheng, L.; Lopez-Beltran, A.; Briganti, A.; Montorsi, F.; et al. Prostate cancer: From Gleason scoring to prognostic grade grouping. Expert Rev. Anticancer Ther. 2016, 16, 433–440. [Google Scholar] [CrossRef]
- Epstein, J.I.; Egevad, L.; Amin, M.B.; Delahunt, B.; Srigley, J.R.; Humphrey, P.A. The 2014 international society of urological pathology (ISUP) consensus conference on gleason grading of prostatic carcinoma definition of grading patterns and proposal for a new grading system. Am. J. Surg. Pathol. 2016, 40, 244–252. [Google Scholar] [CrossRef]
- Van Leenders, G.J.L.H.; Van Der Kwast, T.H.; Grignon, D.J.; Evans, A.J.; Kristiansen, G.; Kweldam, C.F.; Litjens, G.; McKenney, J.K.; Melamed, J.; Mottet, N.; et al. The 2019 International Society of Urological Pathology (ISUP) Consensus Conference on Grading of Prostatic Carcinoma. Am. J. Surg. Pathol. 2020, 44, E87–E99. [Google Scholar] [CrossRef]
- Epstein, J.I.; Amin, M.B.; Fine, S.W.; Algaba, F.; Aron, M.; Baydar, D.E.; Beltran, A.L.; Brimo, F.; Cheville, J.C.; Colecchia, M.; et al. The 2019 genitourinary pathology society (GUPS) white paper on contemporary grading of prostate cancer. Arch. Pathol. Lab. Med. 2020. [Google Scholar] [CrossRef] [PubMed]
- Epstein, J.I.; Kryvenko, O.N. A comparison of genitourinary society pathology and international society of urological pathology prostate cancer guidelines. Eur. Urol. 2021, 79, 3–5. [Google Scholar] [CrossRef] [PubMed]
- Smith, S.C.; Gandhi, J.S.; Moch, H.; Aron, M.; Compérat, E.; Paner, G.P.; McKenney, J.K.; Amin, M.B. Similarities and differences in the 2019 ISUP and GUPS recommendations on prostate cancer grading: A guide for practicing pathologists. Adv. Anat. Pathol. 2021, 28, 1–7. [Google Scholar] [CrossRef]
- Böttcher, R.; Kweldam, C.F.; Livingstone, J.; Lalonde, E.; Yamaguchi, T.N.; Huang, V.; Yousif, F.; Fraser, M.; Bristow, R.G.; van der Kwast, T.; et al. Cribriform and intraductal prostate cancer are associated with increased genomic instability and distinct genomic alterations. BMC Cancer 2018, 18. [Google Scholar] [CrossRef] [PubMed]
- Isaacsson Velho, P.; Silberstein, J.L.; Markowski, M.C.; Luo, J.; Lotan, T.L.; Isaacs, W.B.; Antonarakis, E.S. Intraductal/ductal histology and lymphovascular invasion are associated with germline DNA-repair gene mutations in prostate cancer. Prostate 2018, 8, 401–407. [Google Scholar] [CrossRef] [PubMed]
- Lozano, R.; Salles, D.C.; Sandhu, S.; Aragón, I.M.; Thorne, H.; López-Campos, F.; Rubio-Briones, J.; Gutierrez-Pecharroman, A.M.; Maldonado, L.; di Domenico, T.; et al. Association between BRCA2 alterations and intraductal and cribriform histologies in prostate cancer. Eur. J. Cancer 2021, 147, 74–83. [Google Scholar] [CrossRef] [PubMed]
- Schaeffer, E.; Srinivas, S.; Antonarakis, E.S.; Armstrong, A.J.; Bekelman, J.E.; Cheng, H.; D’Amico, A.V.; Davis, B.J.; Desai, N.; Dorff, T.; et al. Prostate cancer, version 1.2021: Featured updates to the nccn guidelines. JNCCN J. Natl. Compr. Cancer Netw. 2021, 19, 134–143. [Google Scholar] [CrossRef]
- Cimadamore, A.; Cheng, L.; Scarpelli, M.; Lopez-Beltran, A.; Montironi, R. Digital diagnostics and artificial intelligence in prostate cancer treatment in 5 years from now. Transl. Androl. Urol. 2021, 10, 1499–1505. [Google Scholar] [CrossRef]
- Lucas, M.; Jansen, I.; Savci-Heijink, C.D.; Meijer, S.L.; de Boer, O.J.; van Leeuwen, T.G.; de Bruin, D.M.; Marquering, H.A. Deep learning for automatic Gleason pattern classification for grade group determination of prostate biopsies. Virchows Arch. 2019, 475, 77–83. [Google Scholar] [CrossRef] [PubMed] [Green Version]
- Nagpal, K.; Foote, D.; Liu, Y.; Chen, P.H.C.; Wulczyn, E.; Tan, F.; Olson, N.; Smith, J.L.; Mohtashamian, A.; Wren, J.H.; et al. Development and validation of a deep learning algorithm for improving Gleason scoring of prostate cancer. Npj Digit. Med. 2019, 2. [Google Scholar] [CrossRef] [PubMed] [Green Version]
- Montironi, R.; Cimadamore, A.; Lopez-Beltran, A.; Scarpelli, M.; Aurilio, G.; Santoni, M.; Massari, F.; Cheng, L. Morphologic, molecular and clinical features of aggressive variant prostate cancer. Cells 2020, 9, 1073. [Google Scholar] [CrossRef] [PubMed]
- Beltran, H.; Tomlins, S.; Aparicio, A.; Arora, V.; Rickman, D.; Ayala, G.; Huang, J.; True, L.; Gleave, M.E.; Soule, H.; et al. Aggressive variants of castration-resistant prostate cancer. Clin. Cancer Res. 2014, 20, 2846–2850. [Google Scholar] [CrossRef] [Green Version]
- Taplin, M.E.; Rajeshkumar, B.; Halabi, S.; Werner, C.P.; Woda, B.A.; Picus, J.; Stadler, W.; Hayes, D.F.; Kantoff, P.W.; Vogelzang, N.J.; et al. Androgen receptor mutations in androgen-independent prostate cancer: Cancer and leukemia group B study 9663. J. Clin. Oncol. 2003, 21, 2673–2678. [Google Scholar] [CrossRef]
- Gottlieb, B.; Beitel, L.K.; Nadarajah, A.; Paliouras, M.; Trifiro, M. The androgen receptor gene mutations database: 2012 update. Hum. Mutat. 2012, 33, 887–894. [Google Scholar] [CrossRef]
- Aurilio, G.; Cimadamore, A.; Mazzucchelli, R.; Lopez-Beltran, A.; Verri, E.; Scarpelli, M.; Massari, F.; Cheng, L.; Santoni, M.; Montironi, R. Androgen receptor signaling pathway in prostate cancer: From genetics to clinical applications. Cells 2020, 9, 2653. [Google Scholar] [CrossRef]
- Manucha, V.; Henegan, J. Clinicopathologic diagnostic approach to aggressive variant prostate cancer. Arch. Pathol. Lab. Med. 2020, 144, 18–23. [Google Scholar] [CrossRef] [Green Version]
- Kim, D.-H.; Sun, D.; Storck, W.K.; Welker Leng, K.R.; Jenkins, C.; Coleman, D.J.; Sampson, D.A.; Guan, X.; Kumaraswamy, A.; Rodansky, E.S.; et al. BET bromodomain inhibition blocks an AR-Repressed, E2F1-Activated treatment-emergent neuroendocrine prostate cancer lineage plasticity program. Clin. Cancer Res. 2021. clincanres.4968.2020. [Google Scholar] [CrossRef] [PubMed]
- Wu, C.; Peng, S.; Pilie, P.G.; Geng, C.; Park, S.; Manyam, G.C.; Lu, Y.; Yang, G.; Tang, Z.; Kondraganti, S.; et al. PARP and CDK4/6 inhibitor combination therapy induces apoptosis and suppresses neuroendocrine differentiation in prostate cancer. Mol. Cancer Ther. 2021. molcanther.MCT-20-0848-A.2020. [Google Scholar] [CrossRef]
- Montironi, R.; Cheng, L.; Cimadamore, A.; Lopez-Beltran, A. Molecular diagnostics in uro-oncology. Expert Rev. Mol. Diagn. 2020, 20. [Google Scholar] [CrossRef] [Green Version]
- Fisher, W.K.; Montironi, R.; Beltran, A.; Moch, H.; Wang, L.; Scarpelli, M.; Williamson, S.; Koch, M.; Cheng, L. Molecular foundations for personalized therapy in prostate cancer. Curr. Drug Targets 2015, 16, 103–114. [Google Scholar] [CrossRef] [PubMed]
- Robinson, D.; Van Allen, E.M.; Wu, Y.M.; Schultz, N.; Lonigro, R.J.; Mosquera, J.M.; Montgomery, B.; Taplin, M.E.; Pritchard, C.C.; Attard, G.; et al. Integrative clinical genomics of advanced prostate cancer. Cell 2015, 161, 1215–1228. [Google Scholar] [CrossRef] [PubMed] [Green Version]
- Lotan, T.L.; Carvalho, F.L.; Peskoe, S.B.; Hicks, J.L.; Good, J.; Fedor, H.L.; Humphreys, E.; Han, M.; Platz, E.A.; Squire, J.A.; et al. PTEN loss is associated with upgrading of prostate cancer from biopsy to radical prostatectomy. Mod. Pathol. 2015, 28, 128–137. [Google Scholar] [CrossRef] [PubMed]
- Picanço-Albuquerque, C.G.; Morais, C.L.; Carvalho, F.L.F.; Peskoe, S.B.; Hicks, J.L.; Ludkovski, O.; Vidotto, T.; Fedor, H.; Humphreys, E.; Han, M.; et al. In prostate cancer needle biopsies, detections of PTEN loss by fluorescence in situ hybridization (FISH) and by immunohistochemistry (IHC) are concordant and show consistent association with upgrading. Virchows Arch. 2016, 468, 607–617. [Google Scholar] [CrossRef] [PubMed]
- De Bono, J.S.; De Giorgi, U.; Rodrigues, D.N.; Massard, C.; Bracarda, S.; Font, A.; Arija, J.A.A.; Shih, K.C.; Radavoi, G.D.; Xu, N.; et al. Randomized phase II study evaluating AKT blockade with ipatasertib, in combination with abiraterone, in patients with metastatic prostate cancer with and without PTEN loss. Clin. Cancer Res. 2019, 25, 928–936. [Google Scholar] [CrossRef] [PubMed] [Green Version]
- de Bono, J.S.; Bracarda, S.; Sternberg, C.N.; Chi, K.N.; Olmos, D.; Sandhu, S.; Massard, C.; Matsubara, N.; Alekseev, B.; Gafanov, R.; et al. LBA4 IPATential150: Phase III study of ipatasertib (ipat) plus abiraterone (abi) vs. placebo (pbo) plus abi in metastatic castration-resistant prostate cancer (mCRPC). Ann. Oncol. 2020, 31, S1153–S1154. [Google Scholar] [CrossRef]
- Tukachinsky, H.; Madison, R.W.; Chung, J.H.; Gjoerup, O.; Severson, E.A.; Dennis, L.; Fendler, B.J.; Morley, S.; Zhong, L.; Graf, R.P.; et al. Genomic analysis of circulating tumor DNA in 3,334 patients with advanced prostate cancer identifies targetable BRCA alterations and AR resistance mechanisms. Clin. Cancer Res. 2021. [Google Scholar] [CrossRef]
- Deng, J.; Tang, J.; Wang, G.; Zhu, Y.S. Long non-coding RNA as potential biomarker for prostate cancer: Is it making a difference? Int. J. Environ. Res. Public Health 2017, 14, 270. [Google Scholar] [CrossRef] [Green Version]
- Cimadamore, A.; Lopez-Beltran, A.; Massari, F.; Santoni, M.; Mazzucchelli, R.; Scarpelli, M.; Galosi, A.B.; Cheng, L.; Montironi, R. Germline and somatic mutations in prostate cancer: Focus on defective DNA repair, PARP inhibitors and immunotherapy. Future Oncol. 2020, 16, 75–80. [Google Scholar] [CrossRef] [PubMed]
- Vlessis, K.; Purington, N.; Chun, N.; Haraldsdottir, S.; Ford, J.M. Germline testing for patients with BRCA1/2 mutations on somatic tumor testing. JNCI Cancer Spectr. 2020, 4, pkz095. [Google Scholar] [CrossRef] [PubMed] [Green Version]
- de Bono, J.; Mateo, J.; Fizazi, K.; Saad, F.; Shore, N.; Sandhu, S.; Chi, K.N.; Sartor, O.; Agarwal, N.; Olmos, D.; et al. Olaparib for Metastatic Castration-Resistant Prostate Cancer. N. Engl. J. Med. 2020, 382, 2091–2102. [Google Scholar] [CrossRef]
- De Bono, J.S.; Matsubara, N.; Penel, N.; Mehra, N.; Kolinsky, M.P.; Bompas, E.; Feyerabend, S.; Gravis, G.; Joung, J.Y.; Nishimura, K.; et al. Exploratory gene-by-gene analysis of olaparib in patients (pts) with metastatic castration-resistant prostate cancer (mCRPC): PROfound. J. Clin. Oncol. 2021, 39, 126. [Google Scholar] [CrossRef]
- Parker, C.; Castro, E.; Fizazi, K.; Heidenreich, A.; Ost, P.; Procopio, G.; Tombal, B.; Gillessen, S. Prostate cancer: ESMO clinical practice guidelines for diagnosis, treatment and follow-up. Ann. Oncol. 2020, 31, 1119–1134. [Google Scholar] [CrossRef]
- Cornford, P.; van den Bergh, R.C.N.; Briers, E.; Van den Broeck, T.; Cumberbatch, M.G.; De Santis, M.; Fanti, S.; Fossati, N.; Gandaglia, G.; Gillessen, S.; et al. EAU-EANM-ESTRO-ESUR-SIOG guidelines on prostate cancer. Part II—2020 update: Treatment of relapsing and metastatic prostate cancer. Eur. Urol. 2021, 79, 263–282. [Google Scholar] [CrossRef]
- Mottet, N.; van den Bergh, R.C.N.; Briers, E.; Van den Broeck, T.; Cumberbatch, M.G.; De Santis, M.; Fanti, S.; Fossati, N.; Gandaglia, G.; Gillessen, S.; et al. EAU-EANM-ESTRO-ESUR-SIOG guidelines on prostate cancer—2020 update. Part 1: Screening, diagnosis, and local treatment with curative intent. Eur. Urol. 2021, 79, 243–262. [Google Scholar] [CrossRef]
- Su, D.; Wu, B.; Shi, L. Cost-effectiveness of genomic test-directed olaparib for metastatic castration-resistant prostate cancer. Front. Pharmacol. 2021, 11, 2436. [Google Scholar] [CrossRef] [PubMed]
- Cohen, S.A.; Pritchard, C.C.; Jarvik, G.P. Lynch syndrome: From screening to diagnosis to treatment in the era of modern molecular oncology. Annu. Rev. Genom. Hum. Genet. 2019, 20, 293–307. [Google Scholar] [CrossRef]
- Ewing, C.M.; Ray, A.M.; Lange, E.M.; Zuhlke, K.A.; Robbins, C.M.; Tembe, W.D.; Wiley, K.E.; Isaacs, S.D.; Johng, D.; Wang, Y.; et al. Germline mutations in HOXB13 and prostate-cancer risk. N. Engl. J. Med. 2012, 366, 141–149. [Google Scholar] [CrossRef] [PubMed] [Green Version]
- Bever, K.M.; Le, D.T. DNA repair defects and implications for immunotherapy. J. Clin. Investig. 2018, 128, 4236–4242. [Google Scholar] [CrossRef] [PubMed]
- Bou-Dargham, M.J.; Sha, L.; Sang, Q.X.A.; Sang, Q.X.A.; Zhang, J. Immune landscape of human prostate cancer: Immune evasion mechanisms and biomarkers for personalized immunotherapy. BMC Cancer 2020, 20. [Google Scholar] [CrossRef] [PubMed]
- Cimadamore, A.; Cheng, L.; Massari, F.; Santoni, M.; Pepi, L.; Franzese, C.; Scarpelli, M.; Lopez-Beltran, A.; Galosi, A.B.; Montironi, R. Circulating tumor DNA testing for homology recombination repair genes in prostate cancer: From the lab to the clinic. Int. J. Mol. Sci. 2021, 22, 5522. [Google Scholar] [CrossRef]
- Cimadamore, A.; Aurilio, G.; Nolé, F.; Massari, F.; Scarpelli, M.; Santoni, M.; Lopez-Beltran, A.; Cheng, L.; Montironi, R. Update on circulating tumor cells in genitourinary tumors with focus on prostate cancer. Cells 2020, 9, 1495. [Google Scholar] [CrossRef]
- Lourenço, C.; Constâncio, V.; Henrique, R.; Carvalho, Â.; Jerónimo, C. Urinary extracellular vesicles as potential biomarkers for urologic cancers: An overview of current methods and advances. Cancers (Basel) 2021, 13, 1529. [Google Scholar] [CrossRef]
- Merchant, M.L.; Rood, I.M.; Deegens, J.K.J.; Klein, J.B. Isolation and characterization of urinary extracellular vesicles: Implications for biomarker discovery. Nat. Rev. Nephrol. 2017, 13, 731–749. [Google Scholar] [CrossRef] [Green Version]
- Dhondt, B.; Geeurickx, E.; Tulkens, J.; Van Deun, J.; Vergauwen, G.; Lippens, L.; Miinalainen, I.; Rappu, P.; Heino, J.; Ost, P.; et al. Unravelling the proteomic landscape of extracellular vesicles in prostate cancer by density-based fractionation of urine. J. Extracell. Vesicles 2020, 9. [Google Scholar] [CrossRef]
- Mollica, V.; Di Nunno, V.; Cimadamore, A.; Lopez-Beltran, A.; Cheng, L.; Santoni, M.; Scarpelli, M.; Montironi, R.; Massari, F. Molecular mechanisms related to hormone inhibition resistance in prostate cancer. Cells 2019, 8, 43. [Google Scholar] [CrossRef] [Green Version]
- Ciccarese, C.; Santoni, M.; Brunelli, M.; Buti, S.; Modena, A.; Nabissi, M.; Artibani, W.; Martignoni, G.; Montironi, R.; Tortora, G.; et al. AR-V7 and prostate cancer: The watershed for treatment selection? Cancer Treat. Rev. 2016, 43, 27–35. [Google Scholar] [CrossRef]
- Seitz, A.K.; Thoene, S.; Bietenbeck, A.; Nawroth, R.; Tauber, R.; Thalgott, M.; Schmid, S.; Secci, R.; Retz, M.; Gschwend, J.E.; et al. AR-V7 in peripheral whole blood of patients with castration-resistant prostate cancer: Association with treatment-specific outcome under abiraterone and enzalutamide. Eur. Urol. 2017, 72, 828–834. [Google Scholar] [CrossRef] [PubMed]
- Pleskow, H.; Otani, K.; Kusaka, E.; Ukleja, J.; Balza, R.; Fisher, R.; Broderick, K.; Maheswaran, S.; Haber, D.; Saylor, P.J.; et al. Circulating tumor cells and radium-223 response in metastatic castration-resistant prostate cancer. Int. J. Radiat. Oncol. 2020, 108, e534–e535. [Google Scholar] [CrossRef]
- Chatzkel, J.; Mocha, J.; Smith, J.; Zhou, J.M.; Kim, Y.; El-Haddad, G.; Zhang, J. Circulating tumor cells and γh2AX as biomarkers for responsiveness to radium-223 in advanced prostate cancer patients. Future Sci. OA 2019, 6. [Google Scholar] [CrossRef] [PubMed] [Green Version]
- Zhang, T.; Agarwal, A.; Almquist, R.G.; Runyambo, D.; Park, S.; Bronson, E.; Boominathan, R.; Rao, C.; Anand, M.; Oyekunle, T.; et al. Expression of immune checkpoints on circulating tumor cells in men with metastatic prostate cancer. Biomark. Res. 2021, 9. [Google Scholar] [CrossRef] [PubMed]
- Rosellini, M.; Santoni, M.; Mollica, V.; Rizzo, A.; Cimadamore, A.; Scarpelli, M.; Storti, N.; Battelli, N.; Montironi, R.; Massari, F. Treating prostate cancer by antibody-drug conjugates. Int. J. Mol. Sci. 2021, 22, 1551. [Google Scholar] [CrossRef]
- Cimadamore, A.; Cheng, M.; Santoni, M.; Lopez-Beltran, A.; Battelli, N.; Massari, F.; Galosi, A.B.; Scarpelli, M.; Montironi, R. New prostate cancer targets for diagnosis, imaging, and therapy: Focus on prostate-specific membrane antigen. Front. Oncol. 2018, 8, 653. [Google Scholar] [CrossRef] [PubMed] [Green Version]

| Biomarkers | Description | Clinical Impact |
|---|---|---|
| PTEN | PTEN loss is associated with adverse oncological outcomes | By itself or in combination with other biomarkers helps distinguish indolent tumors from those likely to progress |
| APC, RASSF1, TBX15 methylation | DNA methylation biomarkers associated with cribriform architecture and IDC-P | Detection of DNA methylation-based biomarkers may act as indicators of cribriform and/or IDC patterns in biopsy tissue samples |
| SChLAP 1 | Long non-coding RNA overexpressed in 25% of PCa | High expression significantly correlates with metastatic progression of PCa |
| BRCA 2 | BRCA2-mutant PCa harbor increased genomic instability and a mutational profile similar to metastatic rather than localized disease | BRCA2-mutant PCa are uniquely aggressive, often occur in young men, have higher rates of lymph node and distant metastasis, and increased mortality, justifying aggressive initial treatment |
| Tissue Target | Drug | Disease | Strategy | Phase | Estimated Completion Date | NCT Number |
|---|---|---|---|---|---|---|
| PSMA | ARX517 | mCRPC | Single agent | 1 | August 2024 | NCT04662580 |
| STEAP1 | AMG 509 | PCa refractory to a novel antiandrogen therapy and not more than 2 taxane regimens | Single agent | 1 | October 2025 | NCT04221542 |
| TROP2 | Sacituzumab govitecan (IMMU-132) | mCRPC progressing on ARSI | Single agent | 2 | October 2021 | NCT03725761 |
| CD46 | FOR46 | mCRPC | Single agent | 1 | December 2021 | NCT03575819 |
| B7-H3 | MGC018 | Advanced solid tumors including prostate cancer | Single agent or with anti-PD-1 antibody MGA012 | 1/2 | May 2025 | NCT03729596 |
Publisher’s Note: MDPI stays neutral with regard to jurisdictional claims in published maps and institutional affiliations. |
© 2021 by the authors. Licensee MDPI, Basel, Switzerland. This article is an open access article distributed under the terms and conditions of the Creative Commons Attribution (CC BY) license (https://creativecommons.org/licenses/by/4.0/).
Share and Cite
Cimadamore, A.; Mazzucchelli, R.; Lopez-Beltran, A.; Massari, F.; Santoni, M.; Scarpelli, M.; Cheng, L.; Montironi, R. Prostate Cancer in 2021: Novelties in Prognostic and Therapeutic Biomarker Evaluation. Cancers 2021, 13, 3471. https://doi.org/10.3390/cancers13143471
Cimadamore A, Mazzucchelli R, Lopez-Beltran A, Massari F, Santoni M, Scarpelli M, Cheng L, Montironi R. Prostate Cancer in 2021: Novelties in Prognostic and Therapeutic Biomarker Evaluation. Cancers. 2021; 13(14):3471. https://doi.org/10.3390/cancers13143471
Chicago/Turabian StyleCimadamore, Alessia, Roberta Mazzucchelli, Antonio Lopez-Beltran, Francesco Massari, Matteo Santoni, Marina Scarpelli, Liang Cheng, and Rodolfo Montironi. 2021. "Prostate Cancer in 2021: Novelties in Prognostic and Therapeutic Biomarker Evaluation" Cancers 13, no. 14: 3471. https://doi.org/10.3390/cancers13143471
APA StyleCimadamore, A., Mazzucchelli, R., Lopez-Beltran, A., Massari, F., Santoni, M., Scarpelli, M., Cheng, L., & Montironi, R. (2021). Prostate Cancer in 2021: Novelties in Prognostic and Therapeutic Biomarker Evaluation. Cancers, 13(14), 3471. https://doi.org/10.3390/cancers13143471

